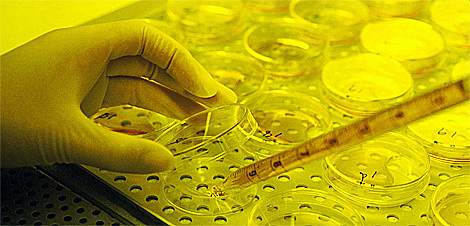
Nanocápsula de oro

-
Erwin Muller inventó el microscopio de misión de campo, que hizo posible conseguir imágenes cercanas a resolución atómica de los materiales.
-
Von Neumann estudió la posibilidad de crear sistemas que se autoreproducen como una forma de costes
-
Jack Kilby de Texas Instruments diseña y construye el primer circuito integrado, por el que posteriormente recibiría el Premio Nobel 2000,
-
Richard Feynman habla por primera vez en una conferencia sobre el futuro de la investigación científica: ¨A mi modo de ver, los principios de la Física no se pronuncian en contra de la posibilidad de maniobrar las cosas átomo por átomo.
-
El científico Japonés Norio Taniguchi empleó por primera vez el término ¨Nanotecnología¨en una conferencia, para describir los procesos de depósitos delgados, con un control dimensional en el orden de nanómetros.
-
Libro: La próxima Era de la Nanotecnología, propone la idea de un ensamblador en nano escala capaz de construir una copia de sí mismo.
H. Rohrer y G. Binning, científicos idearon el microscopio de efecto tunel permite manipular átomos. -
Nanosistemas: ideas sobre la maquinaria molecular y los procesos quimicomecánicos teniedo en cuenta la nanotecnología para construir elementos más pequeños.
-
Se logra convertir a un nanotubo de carbón en un nano lápiz que se puede utilizar para escribir.
-
Naomi Halas, Jennifer west, Rebeca Drezek y Renata Pasqualin desarrollas unas nanocásulas de oro que cuando son sintonizadas para absorber la luz infrarroja cercana, sirven de tratamiento de cáncer de mama sin biopsias invasivas o quimioterapia.
-
Angela Belcher y sus colegas, construyen una batería de iones de litio con un tipo común de virus que no son dañinos para el ser humano y benigno para el ambiente.
-
Nanorex surge como software de manejo de estructuras de mínima escala.
-
Investigadores de la Universidad de Stanford desarrollan el primer equipo de nanotubos de carbono.
A list shows items. A timeline shows sequence.
Use Timetoast to make dates, milestones, and turning points easier to understand in a clear visual format. Timetoast is a timeline maker for work, school, research, and stories.